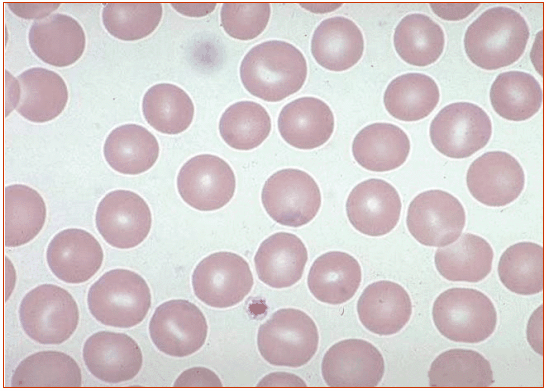

Железодефицитная анемия
При высокой скорости синтеза рецепторов трансферрина происходит угнетение синтеза молекул ферритина
При проведении исследования особые требования предъявляются к технике взятия крови, поскольку неизбежное при этом разрушение эритроцитов и увеличение содержания в сыворотке свободного гемоглобина может оказать существенное влияние на результаты.
) Мазок крови
Для правильной интерпретации СОЭ необходимо исследование мазка периферической крови (рис. 4; 5) поскольку:(1) одновременное наличие клеток малого и большого объема создает представление о нормальном размере эритроцитов;
(2) включение в подсчет ретикулоцитов, имеющих большие размеры, чем зрелые эритроциты, ведет к завышению СОЭ
(3) эритроидные клетки аномальных размеров могут присутствовать в столь малом количестве, что не влияют на вычисляемый СОЭ.Эритроцитометрическая кривая используется для оценки анизоцитоза(вариабельности размеров эритроцитов) и полезна в дифференциальной диагностике анемий с близкими значениями СОЭ. Для железодефицитной анемии характерен низкий СОЭ. Исследование мазка периферической крови имеет решающее значение в диагностике анемий. При приготовлении мазков не должно возникать артефактов. Морфологию эритроцитов лучше изучать в той части мазка, где они расположены в один слой и лишь соприкасаются друг с другом. Важно выявить специфические нарушения морфологии эритроцитов (обсуждаемые при рассмотрении отдельных типов анемии), а также изменения структуры и количества лейкоцитов и тромбоцитов. Исследование мазка периферической крови нередко позволяет установить окончательный диагноз или значительно сузить выбор из возможных нозологических форм, для разграничения которых используют дополнительные исследования. Д. Дополнительные исследования, по возможности, проводят до гемотрансфузии.

Эритроцит - безъядерная клетка, имеющая форму двояковогнутого диска с кольцеобразным утолщением по краям (Рис.4)
Морфология эритроцитов в мазке крови (Рис.5)
) Гематологический анализатор
Это прибор (комплекс оборудования), предназначенный для проведения количественных и качественных исследований крови в клинико-диагностических лабораториях. Бывают автоматические, полуавтоматические.
Число определяемых показателей. Этот параметр в зависимости от модели анализатора варьируется от 8 до 40. Кроме этого анализатор позволяет получать распределения клеток по объему - до 3 гистограмм и до 6 двумерных скэтограмм. Число определяемых показателей является очень важным параметром. Чем больше число определяемых показателей, тем больше диагностической информации получает врач и, следовательно, выше эффективность лечебно-диагностического процесса.
При работе в исследовании был использован автоматический гематологический анализатор CELLTAK F. Специально разработанный для клинических лабораторий и представляет собой полностью автоматизированный прибор. Гематологический анализатор способен обрабатывать десятки образцов в час, с соответствующей спецификации точностью и воспроизводимостью, а также хранить результаты тестов во встроенной памяти и, при необходимости, распечатывать их на встроенном термопринтере. Прибор имеет 22 определяемых показателя (некоторые из них представлены в Табл. 4)
